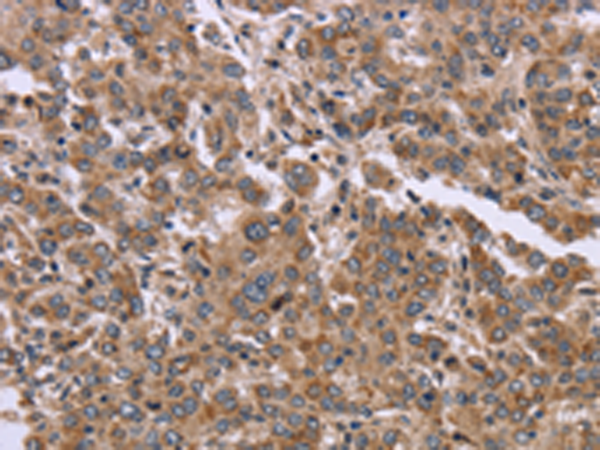
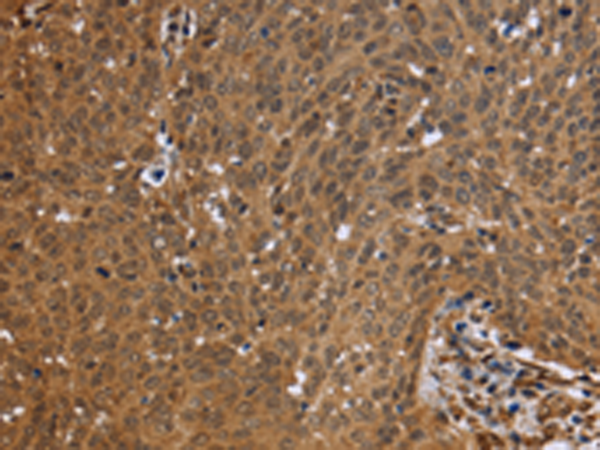

-
分类: 科研抗体货号: P08321别名:应用: IHC反应种属: Human, Mouse, Rat
-
分类: 科研抗体货号: P08304别名: D5D; TU12; FADS6; FADSD5; LLCDL1应用: WB,IHC反应种属: Human, Mouse, Rat
-
分类: 科研抗体货号: P08310别名: MTVR1应用: WB,IHC反应种属: Human, Mouse
-
分类: 科研抗体货号: P08301别名: AMDD应用: IHC反应种属: Human
-
分类: 科研抗体货号: P08320别名: FBP应用: WB,IHC反应种属: Human, Mouse
-
分类: 科研抗体货号: P08309别名: 2-21; ORF9; PANDER; PRED44; C21orf11; C21orf76应用: IHC反应种属: Human, Mouse
-
分类: 科研抗体货号: P08319别名:应用: WB反应种属: Human
-
分类: 科研抗体货号: P08300别名: CVL; CVIL; VIL2; HEL-S-105应用: WB,IHC反应种属: Human, Mouse, Rat
-
分类: 科研抗体货号: P08335别名: DRAL; AAG11; FHL-2; SLIM3; SLIM-3应用: WB,IHC反应种属: Human, Mouse, Rat
-
分类: 科研抗体货号: P08318别名: KIAA0971应用: WB,IHC反应种属: Human

鄂公网安备42018502007531号
鄂公网安备42018502007531号

